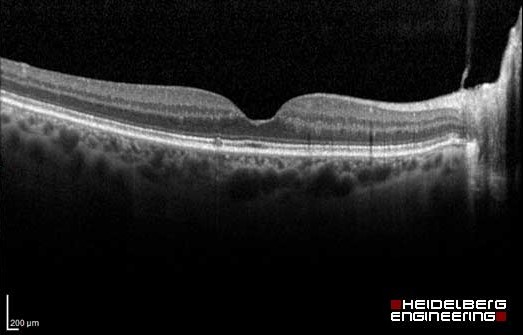
heidelberg-engineering-spectralis-oct.jpg

Contact us for an appointment
At Raison Opticians we offer the latest in eye scanning. The Optical Coherence Tomographer (OCT), photographs and scans the back of the eye, detecting small changes, through the layers of the retina – this allows us to spot abnormalities up to 5 years before a traditional test.
It can spot early signs of:
- Macula conditions including Age-related Macular Degeneration (AMD)
- Glaucoma
- Diabetes - by detecting Diabetic Retinopathy
- Hypertension
The OCT examination is completely non-invasive and painless. Nothing touches your eye at all. It only takes a few seconds, after the Optometrist has taken the scans, they will explain and interpret the results for you.
How much does it cost?
Investing in an OCT screening costs as little as £25 or included with Eyeplan and we highly recommend you have one as part of your regular eye examination. That way you have ultimate peace of mind about your eye health.